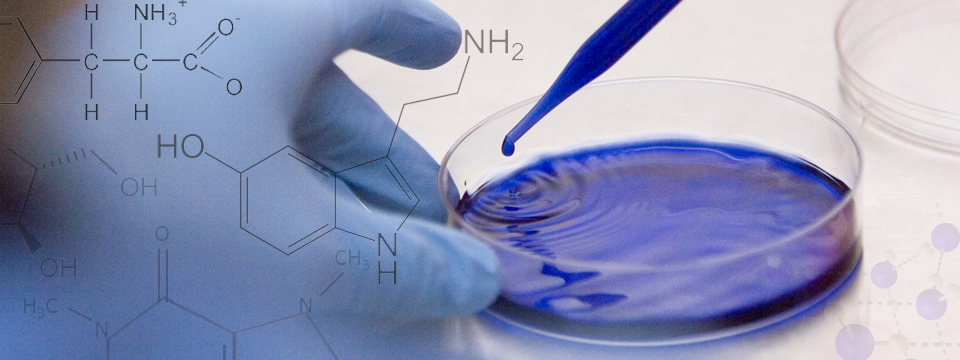

Avantajlar
Yıl içindeki seminerlerle yeni gelişmeleri tanıtmak ve sunmaktayız. Yaşadığımız çevreyi koruyarak çocuklarımıza temiz ve aydınlık bir dünya bırakabilmek için çevre bilincine saygılı olma ilkemizden vazgeçmeyiz.

Müşteri Memnuniyeti
Amacımız hiçbir zaman sadece ürün satmak değildir. Müşterilerimize formül çalışmalarında yardımcı olarak daha kaliteli ürünün uygun ve ekonomik olarak kullanılmasında yardımcı olmak gereğine inanıyoruz.

Neden Hansa Kimya?
Müşterilerimizin memnuniyeti bizim gelecek planlarımız için en önemli faktördür. Müşterilerimizin talep ve ihtiyaçlarına göre her zaman esnek, gelişmeye uygun ve sorun giderici olmak asıl ilkemizdir.

Ana Sayfa Hakkımızda Ürünler Distribütörlük İletişim
Web Tasarım :Webimedya